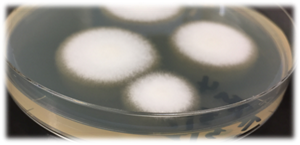
採取してシャーレで培養した白癬菌の写真。

2020年6月30日更新
水虫(足白癬)でご利用者様が転倒?リスクと予防策を知ろう


著者プロフィール/藤谷克己(ふじたに・かつみ)
文京学院大学大学院 保健医療科学研究科 公衆衛生学・疫学 教授、医学博士。
さいたま市高齢者福祉計画等検討委員会・委員、さいたま市地域包括センター運営協議会・会長。ノースカロライナ大学公衆衛生大学院卒業、東京医科歯科大学大学院卒業。
デューク大学特任助教、ノースカロライナ州立大学講師、明治学院大学非常勤講師、日本医科大学兼任講師、新潟県立看護大学院兼任講師といった経歴を持つ。
主な研究課題に、「真菌(足白癬菌)の耐性獲得メカニズムの検証及び菌の環境的特性に関する研究」「ATICSを用いた多職種連携・協働の評価についての国際共同研究」など。著書に、『あなたの医療は安全か?-異業種から学ぶリスクマネジメント』(共著)『アクティブ公衆衛生学ラーニング』(編者)『新版改訂医療リスクマネジメント入門』(単著)。
2019年に在宅医療マッサージ株式会社が高齢者介護施設で働くスタッフ様1,075名を対象に実施した「『高齢者の足のトラブル』に関する調査」(※)によれば、全体の91.1%が「足にトラブルを抱えている利用者がいる」と回答。うち25.1%が「水虫」をトラブル内容に挙げています。
水虫を放置して爪に白癬菌(はくせんきん)が入ると爪がもろくなります。踏ん張りが利きかなくなることで転倒のリスクが高まり、爪が剥がれた場合は歩行困難につながる恐れもあるようです。
そこで今回は、文京学院大学大学院 保健医療科学研究科 教授の藤谷克己氏に、水虫のリスクや予防法を解説いただきます。
水虫とは
水虫の原因
水虫は人を殺さないものの、周りに忌み嫌われる病気です。ちょうど今頃のような梅雨時になると、暑さと湿気で水虫になりやすいと考えがちですが、水虫の原因菌は1年中生息していますので、季節を問わず対策を取ることが大事です。
水虫の原因菌である水虫菌は、学術名をTrichophyton spp.(トリコフィトン属)、和名を白癬菌、病名を足白癬といいます。国内で確認されている主な水虫の菌はTrichophyton mentagrophytes とTrichophyton rubrumの2種類です。
画像1
採取してシャーレで培養した白癬菌(文京学院大学大学院 公衆衛生学教室)
水虫は足・爪・頭などに発症し、中でも足水虫の患者が多いとされています。足水虫は大きく「小水疱型」「趾間型」「角質増殖型」の3つに分けられ、それぞれ症状が異なります。
「小水疱型」水虫になると、足の裏などに小さい水ぶくれができて、痒くなります。「趾間型」はよく見られるジュクジュクするタイプで、足の指と指の間がふやけて皮膚が剥けます。痒みがあり、場合によっては痛みを伴います。「角質増殖型」は足裏やかかとの皮膚が厚くなり、ひび割れたりザラザラしたりします。乾燥して皮脂がなく、痒みはほとんどありません。
ちなみに、ほかにも同じ菌種で同様の症状が現れるものに、たむし(皮膚一般)、いんきん(股部白癬=太股の内側や陰部など)、しらくも(頭部白癬)、体部白癬(上記以外の場所に感染した場合)などがあります。
水虫は人が好き
かつてマリリン・モンローが出演して一世を風靡した『紳士はブロンドがお好き』という映画がありました。「水虫は人が好き」なんです。
水虫の正体は「虫」ではなく真菌という「カビ」です。多くの白癬菌は植物と同じようなものです。ですから、元々は柔らかい土壌、つまり土のような自然の中に多く存在していました。ところが、なぜか前述の2種類は人が好きなのです。このように人が好きな菌を「好人菌」といいます。
白癬菌は環境中でも、数日から数ヶ月も生存し、その間も感染力があるといわれています。水虫を触った手でいろんなところに触れても、そこから他人に感染することがわかっています。
水虫の栄養源は人の角質です。角質は非常に硬いため、白癬菌は分解酵素(ケラチナーゼやMEP等)を分泌することで角質(ケラチン)を分解します。「角質が脱落したもの=垢」が床に落ち、溜まると、白癬菌は「ごちそう」に喜んで飛びつきます。水虫は、白癬菌が落ちた床などをはだしで歩き、足底や指の間に付着したことがきっかけで発症するのです。ちなみにその分解酵素で炎症が起こり、痒みの原因にもなっています。
古代ローマの医師Celsus(ケルスス)は人間に取り付くカビの研究をし、その観察結果を書物に残しました。今でもケルスス禿瘡(とくそう)という病名が使われています。ケルスス禿瘡は、先程説明した頭部白癬という頭にできる皮膚感染症のこと。病気の進行中に化膿性炎症を伴うため、しばしば脱毛が生じます。
水虫が好む環境
英語では水虫をathlete's foot(運動選手の足)といいます。これは「運動選手が」というよりは、「ジムなどのロッカールームやプールといった高温多湿かつ、はだしになりやすい環境にいる人がかかりやすい」という意味から命名されたのではないかと考えています。
高齢者施設において当てはまるのは以下のような環境です。
【水虫が好む場所】
など
水虫を放置すると起こり得るリスク
2016年に我々の研究チームが行った疫学調査で、男性の方が女性よりも白癬菌の保有率(有病率)が高く、かつ年齢が増すごとに保有率が上がることがわかりました。ある地域の複数高齢者施設で行った調査では、一般の水虫保有率は6%程度に対して、高齢者の水虫保有率は50%。施設内での感染疑いも見られました。
水虫は高齢者の転倒リスクを高める
特に気を付けたいのは、白癬菌が爪の中に入ったことで起こる爪白癬の発症です。爪白癬は、足水虫を放置したことで発症するケースが多く、厄介な病気といわれています。元々、爪は皮膚が変性し、硬くなってできたもの。爪の表面は硬いため、軟膏などの塗布薬を塗ったとしても薬の成分が白癬菌まで届きにくく、効き目が悪いです。よって、内服薬で治療します。
爪水虫の治療の過程で、爪が脱落してしまうこともしばしばあります。私が調査でかかわった高齢者施設では、相当な数のお年寄りの足爪がボロボロになり、脱落していました。そうなると踏ん張りが利かず、歩行障害や転倒のリスクが高まります。水虫が原因で足に傷害が生じたりすることがあるほか、糖尿病の患者の場合は治癒に至らず、足趾の切断などにつながることもあります。
水虫はご家族からのクレームにもつながる
施設に入所したご利用者様の顔色はチェックしても、足までチェックするご家族はなかなかいらっしゃいません。気が付いたら水虫がひどくなっていたというケースもあり、「入所後に水虫に感染した」といったクレームを訴えるご家族も少なくありません。
水虫予防対策
足の清潔保持と足・爪のチェックを行う
皮膚に入り込む前の白癬菌は水で洗い流すことができます。ご利用者様に清拭を行うときは、足の指の間と指1本1本を丁寧に拭いてください。
また、足や爪の状態をチェックすることも欠かせません。足の指と指の間の皮が剥けている状態は水虫、白く濁ったり肥厚していたりする場合は爪水虫の可能性があります。こういった状態を見つけたら、特に足爪のチェックを小まめに行ってください。さらに皮膚科医の立場からは、入浴・清拭時に全身の状態をチェックすることをお勧めします。
特に寝たきりになっていらっしゃるご利用者様は自分で足を洗ったり状態を確認したりすることが難しいため、上記を十分に意識しましょう。
保湿ケアを行う
高齢者や女性の場合は、保湿ケアが重要になります。皮膚が乾燥し、ひび割れた状態になると、そこから白癬菌は根を伸ばし、皮膚の奥の方に広がるためです。体内に蓄えられている水分量は年齢とともに低下します。生まれたての小児で80%程度、一般成人で60%ですが、ご高齢者様になると50%以下になります。また、女性は男性に比べ皮下脂肪が多いため、乾燥しやすい傾向があります。
寝具類を小まめに洗濯する
シーツや布団カバーなどの寝具類は小まめに洗濯し、布団などは掃除機で吸引しましょう。
2018年に我々の研究チームが調査を行った結果、ある病院の透析用ベッドのシーツから白癬菌が検出されました。シーツ交換の頻度は1週間に1度とのことだったので、1週間から数日の間、白癬菌が生息していたことになります。ほかの研究チームが行った研究を見ても、施設や家屋の共用部かつ湿気の多い場所から白癬菌が検出されたという報告があります。白癬菌の生息期間はわかっていませんが、環境中で1年程度生息しているという研究報告もあります。この研究はまだ継続しています。
下に示したチェックポイントはご高齢であるご利用者様に対してだけでなく、スタッフ様にも意識していただきたいものになります。
【チェックポイント】
「水虫かな」と思ったら、専門家に相談を
水虫薬は市販で良いお薬が販売されています。しかし、ご利用者様が水虫になっているかどうかを見分けるのはなかなか困難です。
クリニックなどで行う治療は、顕微鏡検査(鏡検)といいます。医師が患部の表膚ないし足の指と指の間から菌を採取、顕微鏡下で菌種を確認してから、治療を進めます。

画像2

画像3
画像2「Trichophyton mentagrophytes」と画像3「Trichophyton rubrum」をプレパラート上で染色し顕微鏡で確認したもの。顕微鏡検査(鏡検)ではこのように確認します。(文京学院大学大学院 公衆衛生学教室)
治療には外用薬の抗菌剤か内服薬の抗菌剤を使いますが、特に爪水虫は、外用薬の浸透性が悪いため内服薬を用いることが多いです。ただしご高齢者様への内服薬投与には、注意が必要になります。さらに、いつ水虫が完治したかといった見極めをスタッフ様が行うのは難しく、判断を誤り途中で投薬を止めてしまうと、完治しません。「水虫かもしれない」と思ったら、必ずお近くの医師に相談してください。
近年、薬で治らない水虫も発見されています。これを薬剤耐性菌といいます。むやみに抗菌薬を多用する、いつまでも使い続けるといった専門家ではない方による判断が影響しているといわれます。現在私たちの研究グループでも薬剤耐性白癬菌の国際共同研究を進めています。最近、その機序も少しずつ明らかになってきました。
メールマガジンにご登録いただくと、
コラムの更新をいち早くお知らせいたします!
営業時間 / 9:00~12:00、13:00~16:00
(土・日・祝日・年末年始・夏季休暇を除く)
![]()
ご返信できますようお客様の氏名、
電話番号、ファクシミリ番号をご記入ください
お電話の混雑状況によって、つながりにくい場合がございますので、
メールによるお問い合わせも併せてご利用ください。
ご不便とご迷惑をおかけいたしますが、ご理解賜りますようお願い申し上げます。
製品の誤飲・誤食、製品が目に入ったなど、緊急の場合は、すぐ医療機関にご相談ください。
また、製品サポート・Q&Aもご参照ください。